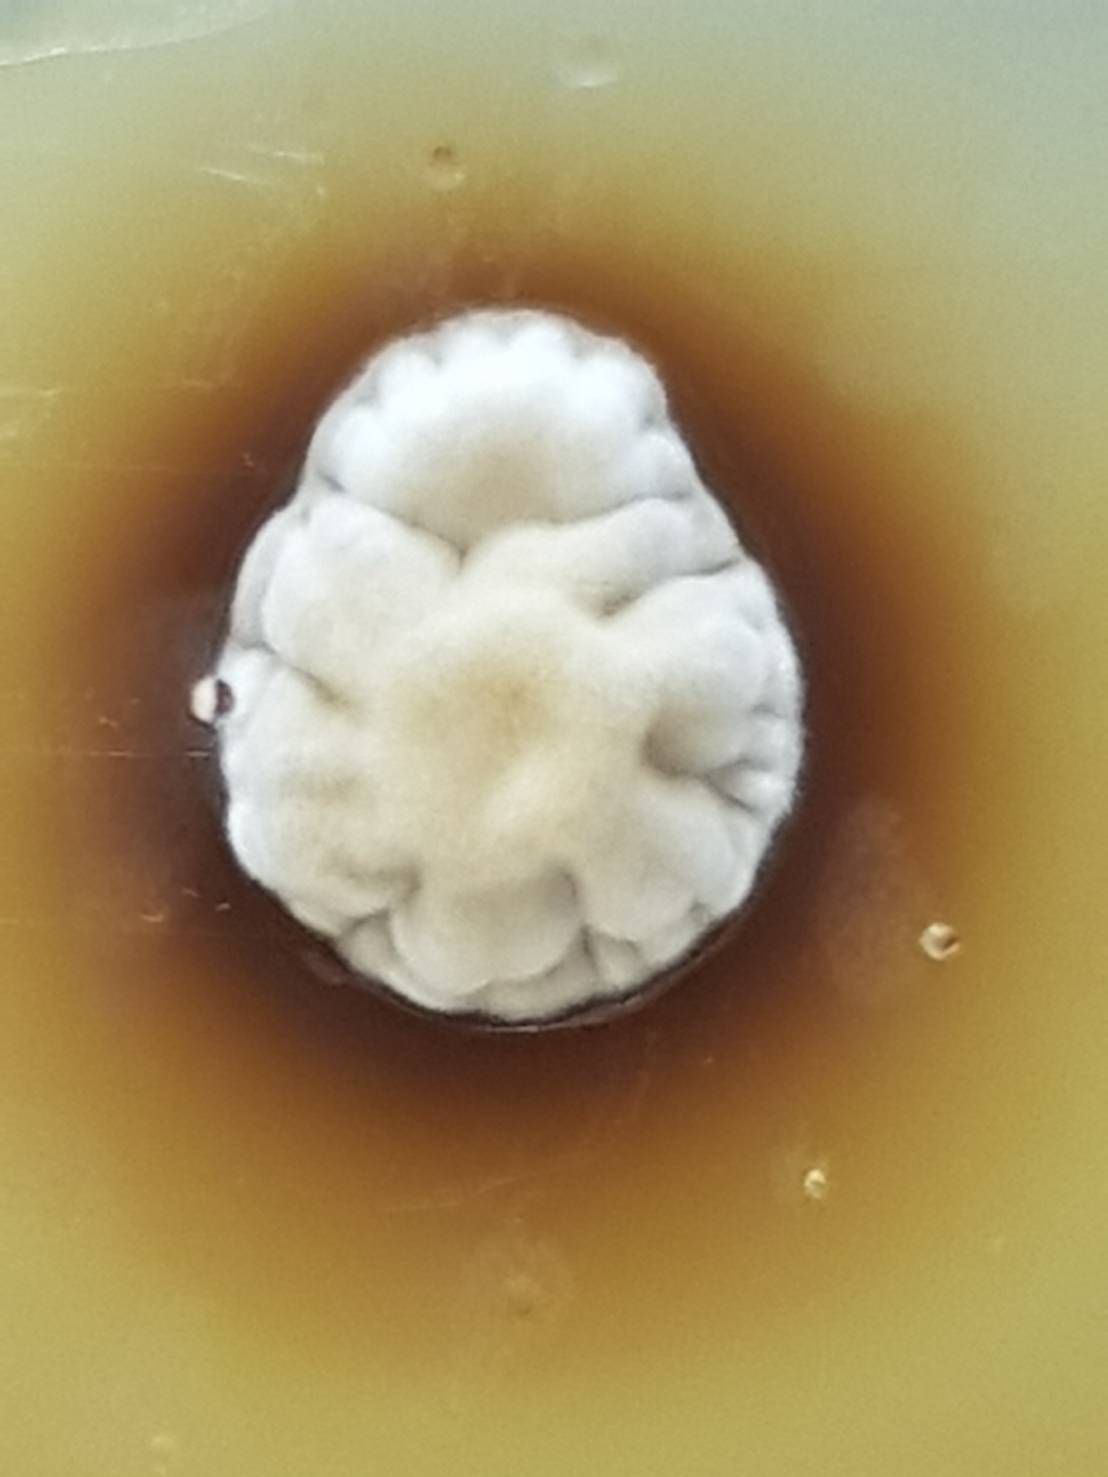

Setting
New Standards
Capability
Cultivation
Our proprietary cultivation system leverages a vegan, nutrient-rich medium to produce premium-quality O.sinensis and C.militaris. Engineered for efficiency, our fast-growing O.sinensis strains typically reach maturity within just four months. Through precise control of environmental conditions and nutrient composition, we maximize the yield and consistency of key bioactive compounds.
Strain Verification
We authenticate our Cordyceps strains using Whole Genome Sequencing (WGS), ensuring true species identity and scientific credibility.
Extraction
Using microwave-and pressure-assisted water extraction method, we extract bioactives from both the fruiting body and growth medium. This method is safe, zero-waste, and free from chemical solvents.
Quality Control
Each production batch undergoes rigorous QC to guarantee a minimum level of key compounds such as cordycepin, adenosine, and polysaccharides.
Tailored Formulation
We fine-tune cultivation conditions to enrich active compounds for specific outcomes: immunity support, skincare, anti-allergy, kidney vitality and more.
turning Nature into Innovation
Isolation from Natural Host
Cordyceps is initially collected from infected caterpillar larvae found in high-altitude regions. The fungal tissue is carefully isolated in a sterile environment
Cultivation
The isolated Cordyceps strain is grown on a nutrient-rich, vegan culture medium under controlled temperature, humidity, and light conditions. This method allows consistent, sustainable production without relying on wild harvesting.
01 isolation
Cordyceps (O.sinensis) is initially collected from infected caterpillar larvae found in high-altitude regions. The fungal tissue is carefully isolated in a sterile environment.
Note. Image from our lab facility.
02 Cultivation
The isolated Cordyceps strain is grown on a nutrient-rich, vegan culture medium under controlled temperature, humidity, and light conditions. This method allows consistent, sustainable production without relying on wild harvesting.
Note. Image from our lab facility.
03 harvesting
Once fully matured (typically in 3–4 months for optimized strains), the fungal biomass is harvested and prepared for processing.
Note. Image from our lab facility.
Purification and Formulation
The extracts are filtered, concentrated, and standardized for consistency. They are then formulated into final products like jellies, capsules, or functional ingredients for health supplements.
04 Extraction
The harvested Cordyceps is subjected to a water-based extraction process to isolate key bioactive compounds such as cordycepin, adenosine, and polysaccharides.
05 Formulation
The extracts are filtered, concentrated, and standardized to ensure consistency and potency. They are then formulated into a range of InnoFalcon products derived from Cordyceps, including fast-acting jellies, tea, topical creams, and functional ingredients used in health supplements and cosmeceuticals.
Technology
Zero-Waste Cultivation
Designed for sustainability, our process leaves no harmful by-products.
Water-Only Extraction
Solvent-free technique preserves purity, safety, and bioactivity of key compounds.
Customizable Bioactive Profiles
Tailored growth conditions to enhance specific compounds for targeted health applications.
Batch-to-Batch Consistency
Rigorous QC ensures minimum levels of core bioactives in every batch.
Scalable & Licensing-Ready
Easily adaptable for industrial production and collaborative technology transfer.
Multi-Industry Applications
Our Cordyceps extracts are versatile—ideal for use in functional foods, dietary supplements, cosmetics, and pharmaceutical formulations.
HOW IT WORKS?
Cordyceps extract is thought to enhance immunity through several scientifically recognized mechanisms
01
Modulation of Immune Cells
Cordyceps contains bioactive compounds, such as polysaccharides, cordycepin, and adenosine, which can activate immune cells like macrophages, natural killer (NK) cells, and T lymphocytes. This activation enhances the body’s ability to detect and fight off pathogens, including bacteria and viruses.
02
Anti-Inflammatory Effects
The extract helps regulate the immune response by reducing excessive inflammation. It does this by modulating the production of pro-inflammatory cytokines, which are signaling proteins that can cause inflammation when present in high levels. This regulation ensures a balanced immune response without overwhelming the body.
03
Stimulation of Cytokine Production
The extract can stimulate the production of beneficial cytokines, such as interferons, which play a key role in activating antiviral defenses. This enhances the body’s readiness to fight off viral infections.
04
Antioxidant Properties
Cordyceps acts as an antioxidant, reducing oxidative stress, which can weaken the immune system. By neutralizing free radicals, it helps maintain the integrity of immune cells and supports a healthy immune environment.
05
Support for the Adaptive Immune System
Cordyceps may help improve the adaptive immune response by supporting the activity of dendritic cells, which are responsible for presenting antigens to T cells. This enhances the body’s ability to recognize and remember pathogens, leading to a more efficient immune response.
“Unlock the full potential of Cordyceps and share its exceptional benefits with individuals and communities worldwide.”